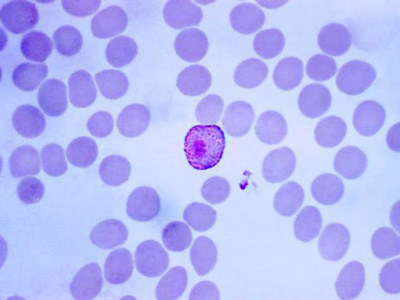

然而在科罗拉多大学癌症中心,Lisa 尝试了一种新的药物组合,这稳定住了她的病情,并提高了生活治疗和时间。科学家们和临床医师利用一种对抗疟疾的药物:氯喹(chloroquine)进行治疗,阻止了癌细胞,重新敏化了她的癌症治疗。除了 Lisa 之外,还有另外两位脑癌患者使用了这一组合治疗,获得了类似的显著疗效。
这一研究成果公布在 1 月 17 日的 eLife 杂志上,文章的第一作者是科罗拉多大学癌症中心,科罗拉多儿童医院肿瘤专家的 Jean Mulcahy-Levy,他们实验室主要的研究领域是细胞自噬,这是一种细胞再循环的过程,被称为自噬体(autophagosomes)的细胞器包裹住多余或者危险的物质,并将其运输到细胞的溶酶体中进行处理。2016 年诺贝尔医学或生理学奖就颁给了这一领域的著名科学家 Yoshinori Ohsumi。
自噬就像是分开了的乐高套件,将不必要的细胞元件组装成用于低能量生存,或逃避病原体攻击的能量块和蛋白。不幸的是,一些癌症也会利用自噬来保护自己不会受到治疗的影响。“我最初的实验研究令人失望,自噬好像不会对脑肿瘤产生很大的影响,但是之后我们发现这种生理过程对肿瘤亚基很有效,”Mulcahy-Levy 说。
研究人员进一步分析发现,癌细胞中基因 BRAF 发生了突变,尤其是 BRAFV600E,这一基因与自噬密切相关,除了最初发现这一突变的黑素瘤之外,上皮胶质母细胞瘤也很有可能携带了 BRAFV600E 突变。有了这些新发现,Mulcahy-Levy 与其他几位研究人员展开了实验分析。这时 Lisa 已经开始用药物 vermurafenib 进行治疗,这一药物最初用于治疗 BRAF + 黑色素瘤,在一段时间的用药之后,癌细胞出现了新的遗传机制,并利用这些机制开始生长。为了阻止癌细胞生长,研究人员提出了一种可能的方法就是预测新的遗传依赖性,然后用另一种靶向方法治疗。“这就像那个把手指放在水坝里的男孩的故事,”Mulcahy-Levy 说,“最终你不能堵住所有的洞。”
研究人员已经知道 Lisa 肿瘤对于 BRAFV600E 突变是阳性的,这标志着肿瘤特别依赖于自噬,而且目前传统的临床实验已经不再适合她,因此他们决定给 Lisa 的治疗中加入抑制自噬的药物氯喹。
“2015 年 9 月,以前的靶向药物都不再起作用了,”Lisa 的父亲 Greg Rosendahl 说,“医生说 Lisa 只有 12 个月的时间了,我们把所有的表兄弟送到阿拉斯加做最后一次旅行,之后他们提出了这个包括氯喹的新组合。”
Vemurafenib 最初将 Lisa 的癌症推到了生存的临界点,然后癌症学会利用自噬将自己从边缘拉了回来,现在我们利用氯喹靶向自噬,vemurafenib 又开始起作用了。
“我的肿瘤变小了,我感觉真棒,”Lisa 说。
“我们已经进行了三个患者的组合治疗,他们都出现了好转,非常令人兴奋,”Mulcahy-Levy 说。
Mulcahy-Levy 的早期研究显示,许多癌症不依赖于自噬。但许多患者由于已经使用了安全简单的药物来抑制自噬,那么之后的这种自噬依赖性癌症出现与需要添加氯喹进行治疗之间的时间间隔就会变短。
“我真的很喜欢能够为患者量身定制治疗,”Mulcahy-Levy 说,“我喜欢说‘我认为这对你来说非常重要 ',而不用对另一个癌症患者进行同样的治疗,癌症是由不同的遗传改变驱动的,这是以患者为中心的治疗。”
原文链接:Autophagy inhibition overcomes multiple mechanisms of resistance to BRAF inhibition in brain tumors.
原文摘要:
Kinase inhibitors are effective cancer therapies, but tumors frequently develop resistance. Current strategies to circumvent resistance target the same or parallel pathways. We report here that targeting a completely different process, autophagy, can overcome multiple BRAF inhibitor resistance mechanisms in brain tumors. BRAFV600Emutations occur in many pediatric brain tumors. We previously reported that these tumors are autophagy-dependent and a patient was successfully treated with the autophagy inhibitor chloroquine after failure of the BRAFV600E inhibitor vemurafenib, suggesting autophagy inhibition overcame the kinase inhibitor resistance. We tested this hypothesis in vemurafenib-resistant brain tumors. Genetic and pharmacological autophagy inhibition overcame molecularly distinct resistance mechanisms, inhibited tumor cell growth, and increased cell death. Patients with resistance had favorable clinical responses when chloroquine was added to vemurafenib. This provides a fundamentally different strategy to circumvent multiple mechanisms of kinase inhibitor resistance that could be rapidly tested in clinical trials in patients with BRAFV600E brain tumors.
扫描上面二维码在移动端打开阅读